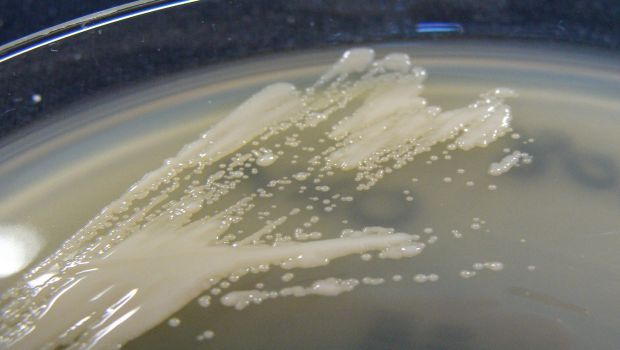

The antibiotic-resistant Acinetobacter baumannii bacterium is one of the most globally harmful bacteria that causes nosocomial infections. Researchers at the University of Turku have discovered that the bacterium attaches to plastic medical devices using tiny finger-like structures. The researchers were able to develop antibodies that prevent the bacterial spread.
Infections related to hospitals and medical devices form major healthcare problems worldwide. These infections are associated with the ability of pathogens to colonise both biotic and abiotic surfaces.
- The pan-antibiotic resistant Acinetobacter baumannii is one of the most troublesome pathogens for healthcare institutions globally and currently tops the World Health Organization's priority pathogens list for the development of new antibiotics, says leader of the research group of the Joint Biotechnology Laboratory Anton Zavialov from the Department of Chemistry of the University of Turku.
The research group discovered a unique molecular mechanism that enables Acinetobacter baumannii and related pathogenic bacteria to colonise medical devices. This mechanism enables the bacteria to spread in hospitals.
- This discovery makes it possible for hospitals to reduce pathogen spread through simple and economical procedures, says Zavialov.
Acinetobacter baumannii is capable of colonizing medical devices by means of archaic chaperone-usher (ACU) pili. ACU pili are hair-like protein structures found on the surface of many pathogenic bacteria. Using X-ray crystallography, the researchers found three finger-like loops at the tips of the pili. These "fingers" stick extremely tightly to hydrophobic plastics which are commonly used in medical devices and tools.
- We believe that these fingers are attached into small cavities on the surfaces. This hypothesis could explain why the bacteria spread and attach so strongly to so many different hydrophobic materials, notes Zavialov.
The researchers produced antibodies that bind to the tips of the pili and completely block the bacterial attachment and biofilm formation.
- The use of hydrophilic materials instead of hydrophobic plastics in medical devices is another simple and economical solution to reduce pathogen spread, says Zavialov.
Another antibiotic-resistant pathogen, Pseudomonas aeruginosa, has similar pili, and it forms similar biofilms. The researchers predict that the means suggested for battling A. baumannii might also be applied to control the spread of P. aeruginosa infections and possibly also battle against several other pathogens that use ACU pili.
Source: University of Turku
Stay prepared and protected with Infection Control Today's newsletter, delivering essential updates, best practices, and expert insights for infection preventionists.